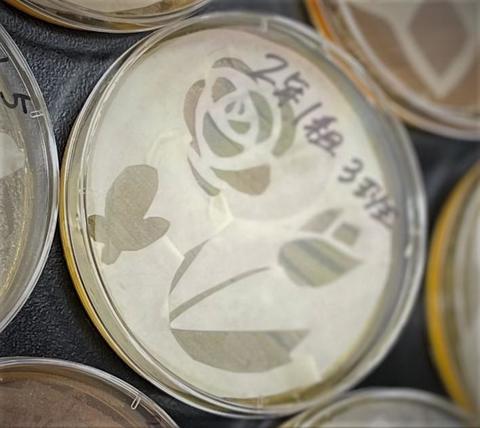

- ホーム
- Webオープンキャンパス
- 学生募集、入試情報
オープンキャンパス - 大学案内
- 大学案内について
- 大学概要
- 学生サポート
- 進路支援
- 健康支援
- 付属図書館
- 地域連携
- ボランティア活動
- あやな会
- 付属みどり野幼稚園
- インフォメーション
- 学科・専攻科
- 学科・専攻科について
- 健康福祉学科
- 経営情報学科
- 幼児教育学科
- 食物栄養学科
- 専攻科食物栄養専攻
- キャンパスライフ
- キャリア・就職
- 公開講座
- 訪問者別メニュー
- お問い合わせ
News
「食品衛生学実験」では、食品の安全性に関与する種々の要因について実験を行っています。
第14回(2022(令和4)年7月22日(金)、7月27日(水))、第15回(2022(令和4)年7月29日(金)、8月2日(火))の授業では、食物栄養学科の2年生が、ディスク拡散法および黄色ブドウ球菌の塩に強い性質を応用して、「バイオアート」を作成しました。
<製作過程を一部ご紹介>
作成中

完成
<作品を一部ご紹介>


完成した自分達の作品を見て、学生達からは、驚きの声が上がっていました。
最近の投稿